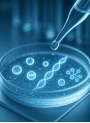

สารออกฤทธิ์ใน Skin Balancing Pore-Reducing Toner
ถามโดย: rich999_pongtong
เมื่อ: August 18, 2016
ประเภทผลิตภัณฑ์:
เครื่องสำอาง
Answered
คำถาม
สอบถามเกี่ยวกับสารออกฤทธิ์หลักใน Skin Balancing Pore-Reducing Toner ว่ามีอะไรบ้าง และแต่ละชนิดมีคุณสมบัติและประโยชน์ต่อผิวอย่างไร?
คำตอบ
สารออกฤทธิ์หลักใน Skin Balancing Pore-Reducing Toner
จากรายการส่วนผสมและข้อมูลที่ได้รับ สารออกฤทธิ์หลักใน Skin Balancing Pore-Reducing Toner ได้แก่:
- Niacinamide (วิตามินบี 3): มีคุณสมบัติช่วยลดเลือนริ้วรอย ลดรอยแดง/รอยดำ (hyperpigment) เพิ่มความชุ่มชื้นให้ผิวโดยกระตุ้นการสร้างคอลลาเจนและเซราไมด์ เสริมเกราะป้องกันผิวให้แข็งแรง และช่วยควบคุมความมันบนใบหน้า เหมาะสำหรับผิวที่เป็นสิว นอกจากนี้ยังช่วยเรื่องรอยคล้ำใต้ตาที่เกิดจากการไหลเวียนโลหิตไม่ดีได้
- Adenosine Triphosphate (ATP): เป็นส่วนประกอบสำคัญในการทำงานของเซลล์ผิว มีประสิทธิภาพในการลดเลือนริ้วรอยและช่วยสมานแผล โดยให้พลังงานแก่ผิวในการซ่อมแซมตัวเอง
- Chamomile Water (Anthemis Nobilis) Flower Extract: ทำหน้าที่เป็นสารต้านการระคายเคือง ช่วยปลอบประโลมและทำให้ผิวรู้สึกสบาย
- Hydrolyzed Jojoba Esters: เป็นส่วนผสมช่วยฟื้นฟูผิวที่ได้จาก Jojoba
- Hydrolyzed Vegetable Protein: มีคุณสมบัติให้ความชุ่มชื้นและช่วยปกป้องผิวจากการระคายเคือง
- Sodium PCA: เป็นส่วนหนึ่งของ Natural Moisturizing Factors (NMF) ที่เกิดขึ้นตามธรรมชาติในผิวหนัง ช่วยปรับสมดุลและให้ความชุ่มชื้นแก่ผิว ป้องกันการสูญเสียน้ำที่ทำให้ผิวแห้งกร้านและเกิดริ้วรอยก่อนวัย และกระตุ้นให้ผิวแข็งแรงและชุ่มชื้น
- Panthenol (โปรวิตามินบี 5): ทำหน้าที่เป็นสารให้ความชุ่มชื้น (humectant) ช่วยกักเก็บความชื้น เสริมเกราะป้องกันผิว ลดการอักเสบ รอยแดง การคัน ช่วยสมานแผล และเร่งการสร้างเซลล์ผิวใหม่
- Sodium Hyaluronate: เป็นรูปแบบหนึ่งของ Hyaluronic Acid ที่ช่วยให้ความชุ่มชื้นแก่ผิว
- เซราไมด์ (Ceramide 3, Ceramide 6 II, Ceramide 1), Phytosphingosine และ Cholesterol: เป็นส่วนผสมกลุ่มไขมันที่ช่วยฟื้นฟูผิว ซึ่งเป็นส่วนประกอบสำคัญของเกราะป้องกันผิว ช่วยฟื้นฟูผิวที่แห้งกร้านและมีอายุ ปกป้องผิวจากสารระคายเคืองและสารก่อภูมิแพ้ และป้องกันการสูญเสียความชุ่มชื้น
- Tetrahexyldecyl Ascorbate (วิตามินซี): เป็นวิตามินซีชนิดละลายในน้ำมัน ซึ่งเป็นสารต้านอนุมูลอิสระที่มีประสิทธิภาพสูง ช่วยให้ผิวแลดูกระจ่างใส ลดความเสียหายของ DNA ที่เกิดจากแสง UV และกระตุ้นการสังเคราะห์คอลลาเจนในผิว
ส่วนผสมเหล่านี้ทำงานร่วมกันเพื่อให้ความชุ่มชื้น เสริมสร้างเกราะป้องกันผิว ลดการระคายเคือง และให้ประโยชน์ในการต่อต้านริ้วรอยและทำให้ผิวกระจ่างใสขึ้น